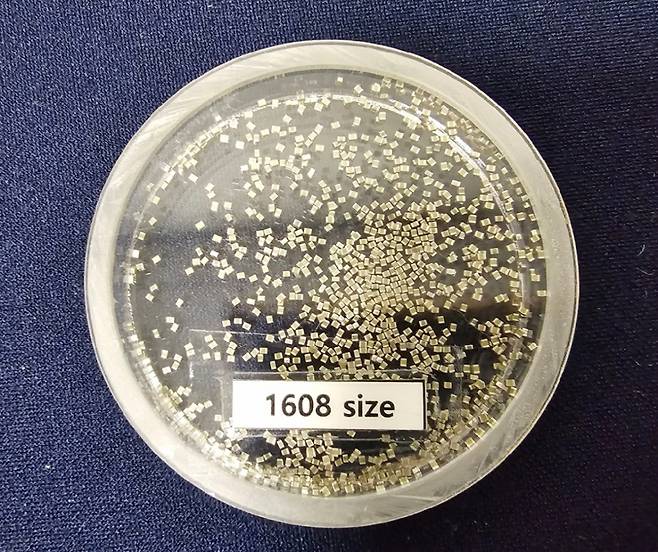
(서울=뉴스1) 한재준 기자 = 삼성전기의 적층세라믹콘덴서(MLCC)제품. 500cc 와인잔에 가득 채운 MLCC 가격은 3억 원에 달한다. 2024.10.30/뉴스1  Copyright (C) 뉴스1. All rights reserved. 무단 전재 및 재배포,  AI학습 이용 금지. /사진=(서울=뉴스1) 한재준 기자

외국인들이 먼저 알아본 삼성전기…AI 바람 타고 연일 고점 경신
전체 맥락을 이해하기 위해서는 본문 보기를 권장합니다.
삼성전기 주가가 주력 제품인 적층세라믹콘덴서(MLCC) 업황 회복 기대감에 힘입어 올들어 45% 급등했다.
MLCC는 반도체의 원할한 구동을 돕는 부품으로 인공지능(AI) 수요 확대로 중요성이 부각됐다.
이 글자크기로 변경됩니다.
(예시) 가장 빠른 뉴스가 있고 다양한 정보, 쌍방향 소통이 숨쉬는 다음뉴스를 만나보세요. 다음뉴스는 국내외 주요이슈와 실시간 속보, 문화생활 및 다양한 분야의 뉴스를 입체적으로 전달하고 있습니다.
![[서울=뉴시스] 정병혁 기자 = 장덕현 삼성전기 대표이사 사장이 30일 서울 중구 신라호텔에서 열린 2025년 삼성호암상 시상식에 참석하고 있다. 2025.05.30. jhope@newsis.com /사진=정병혁](https://img2.daumcdn.net/thumb/R658x0.q70/?fname=https://t1.daumcdn.net/news/202509/04/moneytoday/20250904134049626oyxb.jpg)
삼성전기 주가가 주력 제품인 적층세라믹콘덴서(MLCC) 업황 회복 기대감에 힘입어 올들어 45% 급등했다. MLCC는 반도체의 원할한 구동을 돕는 부품으로 인공지능(AI) 수요 확대로 중요성이 부각됐다. 증권가가 목표주가를 잇달아 상향한 가운데 외국인 투자자들이 매수세를 주도했다.
4일 삼성전기는 코스피시장에서 전일(17만4200원) 대비 3.04% 오른 17만9500원에 거래됐다. 이는 지난해 연말 대비 44.98% 오른 것으로 52주 신고가다. 삼성전기는 지난 1일부터 3거래일 연속 고점을 경신했다.
특히 7월 30일에는 삼성전자와 테슬라 간 AI(인공지능) 반도체 공급 계약 수혜주로 부각되며 하루에만 10% 이상 급등했다.
외국인은 올 들어 전날까지 삼성전기를 3758억원어치 순매수했다. 기관도 1117억원 순매수였다. 다만 개인(일반 개인 투자자)은 4783억원어치 순매도로 나타났다.
MLCC 업황과 테슬라에 대한 파운드리(반도체 위탁생산) 공급 이슈를 외국인이 보다 예민하게 투자 신호로 받아들인 것으로 보인다. MLCC는 글로벌 AI 확산과 전장 시장 성장세로 인해 글로벌 시장에서 중요성이 부각돼 왔다.
증권업계에서는 MLCC 고도화 경쟁에서 삼성전기가 글로벌 선두권을 유지할 경우 주가 상승세도 이어질 가능성이 크다고 본다. MLCC시장에 대해 수요보다 공급이 적어 가격 협상력이 공급자에 있는 공급자 우위 시장이 예상된다는 분석도 있다. 단기적으로는 외국인들이 추격 매수와 차익 실현 가운데 어느쪽을 선택할지 주목된다.
증권사 가운데 키움증권, iM증권, 하나증권이 삼성전기에 대한 목표주가를 20만원 이상으로 상향했다.
김민경 하나증권 연구원은 "산업 및 전장용(자동차 전자장치용) MLCC 수급이 타이트해지면서 삼성전기 밸류에이션(기업가치 평가)의 리레이팅(재평가)이 가능한 구간이 도래했다"며 "AI 서버 신제품 출시, 800G 네트워크 확산 등을 고려하면 내년 MLCC 시장은 공급자 우위 국면으로 전개될 가능성이 높다"고 했다.
김소원 키움증권 연구원도 "AI 서버와 네트워크 장비 수요 확대가 MLCC와 패키지 기판(반도체를 실장하기 위한 기판) 사업부의 수혜로 이어지며 전사 실적 성장을 이끌고 있다"며 "내년에는 하이퍼스케일러(초대형 IT 기업) 고객사 내 점유율이 확대되고 신규 고객사향 공급도 예상돼 성장 수혜가 더욱 커질 것"이라고 했다.
김지훈 기자 lhshy@mt.co.kr
Copyright © 머니투데이 & mt.co.kr. 무단 전재 및 재배포, AI학습 이용 금지.
- 신지, 문원과 결혼 앞두고 결국 눈물…신혼집 마련에 "실감 안 나" - 머니투데이
- "이수혁 사람 취급도 안 해" 팬 분노…중국 팬미팅서 땀 뻘뻘, 무슨 일 - 머니투데이
- MC몽, 이승기·이다인 부부 만났다…"극심한 우울증" 극복했나 - 머니투데이
- 이웃 된 전남편·상간녀, 딸 보란 듯 문 '활짝'…속내는 따로 있었다 - 머니투데이
- 남편 불륜 대신 빌던 시모 뒤통수…"돈 잘버는 상간녀 몰래 도와" - 머니투데이
- 테슬라·BYD, 지금처럼 보조금 못받는다 - 머니투데이
- '돈가스 무한리필' 8000원 식당의 경고..."김치통에 26장, 이젠 안 참아" - 머니투데이
- '깜짝 실적' 삼전 다음은 여기..."쌀 때 줍자" 2차전지주 우르르 - 머니투데이
- "미친 X, 해협 열어" 트럼프 폭언 "제정신이냐"…공화당도 '곤혹' - 머니투데이
- [속보]강훈식 "호르무즈해협 대기 중인 선박 선원 안전, 최우선 전제 하에 통과 방안 마련 중" -